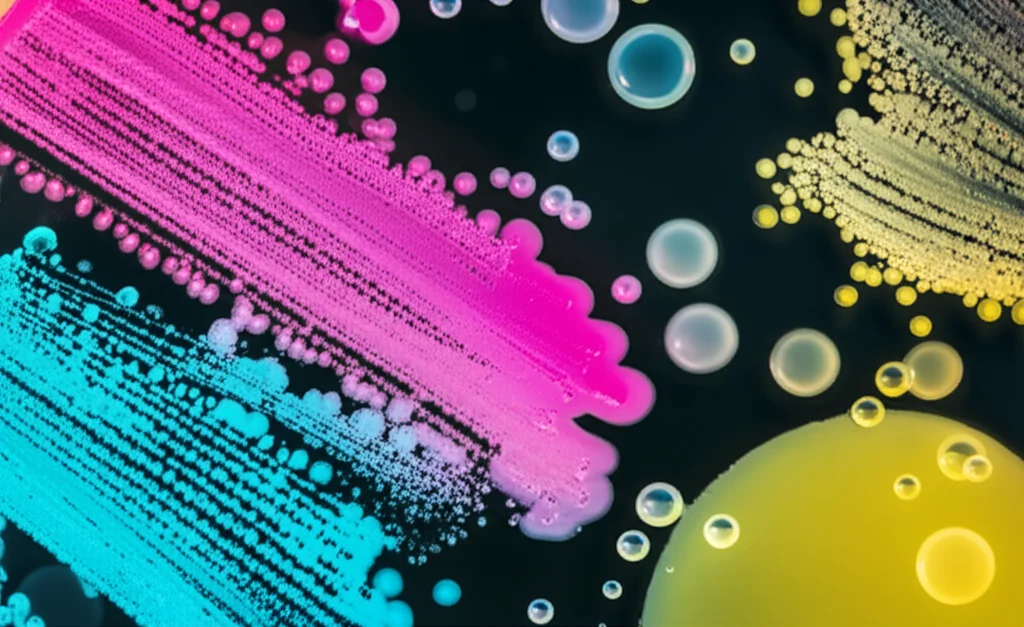
Macro fotografia di diverse colonie batteriche colorate (rosa, blu, gialle) su una piastra di Petri scura. Alcune colonie appaiono rigogliose, altre diradate. Goccioline trasparenti stilizzate, rappresentanti i pesticidi, sono sparse sulla superficie. Illuminazione da laboratorio controllata per evidenziare i dettagli, obiettivo macro 90mm, alta definizione dei contorni batterici.

Pesticidi e Microbiota: Cosa Succede Davvero nella Nostra Pancia?
Ciao a tutti! Oggi voglio parlarvi di qualcosa che, ammettiamolo, un po’ ci preoccupa tutti: i pesticidi. Li usiamo in agricoltura per avere cibi più belli e abbondanti, ma che fine fanno una volta che arrivano nel nostro corpo? E soprattutto, come reagiscono i miliardi di piccoli amici che ospitiamo nel nostro intestino, il famoso microbiota intestinale? Beh, mettetevi comodi, perché sto per raccontarvi una storia affascinante, basata su una ricerca scientifica fresca fresca, che ha cercato di fare luce proprio su questo.
I pesticidi: non solo una questione di residui
Sappiamo che i residui di pesticidi possono finire nel suolo, nell’acqua, nell’aria e, di conseguenza, nel nostro cibo e nelle nostre bevande. Il nostro tratto gastrointestinale è una delle prime porte d’ingresso per queste sostanze. Ma non è solo una barriera passiva; è un vero e proprio ecosistema brulicante di vita, con circa 100 trilioni di cellule microbiche! Questo “organo” aggiuntivo è fondamentale per la nostra digestione, per l’assimilazione dei nutrienti, per il sistema immunitario e persino per il nostro umore. Se questo delicato equilibrio, chiamato eubiosi, si rompe (disbiosi), possono insorgere un sacco di problemi: diabete, asma, obesità, Alzheimer e persino alcuni tipi di cancro. Fino a poco tempo fa, quando si parlava di danni da pesticidi, si pensava soprattutto allo stress ossidativo. Ma ora, l’attenzione si sta spostando sempre più sull’effetto diretto che queste sostanze hanno sul nostro microbiota.
Cosa hanno scoperto i ricercatori? Un’indagine approfondita
Immaginatevi un laboratorio super attrezzato dove gli scienziati hanno messo “faccia a faccia” diciotto diversi pesticidi (alcuni ancora usati, altri un po’ controversi come il DDT o l’atrazina) con diciassette specie rappresentative di batteri che popolano il nostro intestino. Hanno scelto batteri appartenenti ai gruppi più abbondanti, come Bacteroidetes e Firmicutes, ma anche Actinobacteria e Proteobacteria, per avere un quadro il più completo possibile.
Effetti sulla crescita: chi vince e chi perde
La prima cosa che hanno osservato è come i pesticidi influenzano la crescita di questi batteri. Ebbene, i risultati sono stati sorprendenti! Alcuni batteri, come B. stercoris (un Gram-negativo) o E. lenta, C. symbiosum e C. scidens (Gram-positivi), hanno mostrato una crescita addirittura promossa dall’esposizione a certi pesticidi, a concentrazioni tra 0.05 e 1 µg/mL. Altri, invece, ben sei specie Gram-negative (tra cui B. vulgatus e B. fragilis) e cinque Gram-positive (come C. perfringens e B. adolescentis), hanno subito un’inibizione della crescita.
Pensate, ad esempio, al 4,4′-DDE (un metabolita del DDT): a seconda della concentrazione, ha inibito la crescita di 11 specie batteriche, ne ha promosse 3, e per altre 3 l’effetto cambiava proprio in base a quanto pesticida c’era! Questo ci dice che la risposta dei batteri ai pesticidi è specifica per ogni specie e dipende dalla dose. Non è un “tutti uguali di fronte al pesticida”.
Batteri spugna: l’accumulo di pesticidi
E non è finita qui! I ricercatori hanno scoperto che i nostri batteri intestinali possono anche bioaccumulare i pesticidi. Dopo un’esposizione di 12 ore, otto dei dieci pesticidi rilevati (molti dei quali sono inquinanti organici persistenti o interferenti endocrini) si sono accumulati nelle cellule batteriche. Specie come C. bolteae e B. ovatus si sono rivelate particolarmente “brave” in questo. Questo potrebbe spiegare perché i residui di pesticidi persistono così a lungo nel nostro corpo: i batteri li trattengono! Insomma, questi dati confermano che i pesticidi non solo alterano la composizione del microbiota, ma l’accumulo batterico aumenta il rischio di un’esposizione prolungata.
Il metabolismo batterico va in tilt: la scoperta dei metaboliti alterati
Ma la vera rivoluzione di questo studio, secondo me, è l’analisi metabolomica. In pratica, i ricercatori sono andati a vedere come cambia il “linguaggio chimico” dei batteri, cioè quali sostanze producono o consumano, quando vengono esposti ai pesticidi. Hanno identificato oltre 468 metaboliti coinvolti! Sei specie batteriche si sono dimostrate particolarmente sensibili, con il maggior numero di metaboliti alterati: B. ovatus, B. uniformis, D. formicigenerans, B. stercoris, C. symbiosum e B. adolescentis.
Le alterazioni metaboliche hanno toccato ben 40 vie metaboliche, tra cui quelle fondamentali per la sintesi degli acidi nucleici (DNA e RNA) e il metabolismo degli amminoacidi, come il metabolismo delle pirimidine e delle purine, il metabolismo dell’arginina e prolina, e la degradazione della lisina. Pensate a quanto sono cruciali queste vie per la vita e la crescita cellulare! Questo ci dà un’idea a livello molecolare di come i pesticidi possano influenzare la crescita dei microbi intestinali.
Focus su vie metaboliche chiave: Triptofano, Propanoato e Acidi Biliari
Lo studio ha messo in luce come i pesticidi impattino direttamente vie metaboliche cruciali per la nostra salute:
- Metabolismo del triptofano: Questo amminoacido è precursore della serotonina (l’ormone del buonumore) e di altre molecole importanti come l’indolo e i suoi derivati, che modulano le risposte immunitarie e infiammatorie. Ben dieci specie batteriche hanno mostrato alterazioni in questa via! Per esempio, in B. ovatus, l’esposizione ai pesticidi ha causato una diminuzione di L-triptofano e un aumento di indolo e acido indolo-3-acetico.
- Metabolismo del propanoato: Il propanoato è un acido grasso a catena corta (SCFA) prodotto dai batteri, fondamentale per la salute dell’intestino e con effetti sistemici. Anche qui, diverse specie batteriche hanno mostrato una produzione disregolata.
- Metabolismo degli acidi biliari: Gli acidi biliari, modificati dai batteri, sono cruciali per la digestione dei grassi e agiscono come molecole segnale. I pesticidi possono interferire anche con questo processo.
La cosa interessante è che i pesticidi possono influenzare le stesse vie metaboliche in batteri diversi inducendo però la produzione disregolata di metaboliti distinti all’interno di quelle vie. Una complessità incredibile!

La saga dei lipidi: un mondo grasso sotto attacco
Il nostro microbiota è anche un grande produttore e trasformatore di lipidi bioattivi, molecole “grasse” con funzioni strutturali e di segnalazione che influenzano il nostro metabolismo e sistema immunitario. Dato che alcuni pesticidi sono noti interferenti endocrini, i ricercatori hanno voluto vederci chiaro, conducendo un’analisi lipidomica completa. E cosa hanno trovato? Che i batteri Gram-positivi e Gram-negativi rispondono in modo diverso, e che i pesticidi tendono a raggrupparsi, suggerendo una similarità funzionale nel modo in cui alterano il metabolismo lipidico.
Le categorie di lipidi più colpite sono state i glicerofosfolipidi (GP) e i glicerolipidi (GL), specialmente in batteri come B. stercoris, C. scindens e C. symbiosum. Questo non sorprende, dato che i GP sono abbondanti nelle membrane cellulari batteriche, la prima linea di difesa contro gli “attacchi” esterni. A livello di classi lipidiche, sono state osservate influenze significative su acilcarnitine, diacilgliceroli e ceramidi.
Un’altra scoperta affascinante riguarda le catene degli acidi grassi. Nei mammiferi, dominano i lipidi con catene a numero pari di atomi di carbonio, ma i batteri presentano una maggiore diversità, con catene sia pari che dispari (es. C15, C17 vs C16, C20). Dopo l’esposizione ai pesticidi, sono stati osservati cambiamenti significativi nelle quantità di acidi grassi C15:0, C16:0, C17:0 e C17:1. L’acido arachidico (C20:0), un acido grasso saturo, potrebbe addirittura diventare un bioindicatore sensibile dell’esposizione dei batteri intestinali ai pesticidi. Pensate che il C9:0 può regolare la barriera immunologica epiteliale!
Inoltre, è noto che il lipide A (un’endotossina), componente del lipopolisaccaride (LPS) presente nei batteri Gram-negativi, contiene tipicamente catene idrossiaciliche C14, C16 e C18. Lo studio ha osservato cambiamenti significativi in C14:0, C16:0 e C18:1 nei GP e GL, specialmente nel batterio Gram-negativo B. stercoris. Questo fa ipotizzare che i pesticidi possano disregolare i livelli di questi lipidi, portando a una potenziale alterazione del lipide A o LPS, e influenzando indirettamente il sistema immunitario dell’ospite.
Dalla provetta al topo: la conferma in vivo
Per capire se quello che succede in laboratorio si riflette anche in un organismo vivente, i ricercatori hanno condotto uno studio su topi. Hanno scelto il batterio B. ovatus (uno dei più colpiti e grande accumulatore di pesticidi) e il pesticida 4,4′-DDE. Hanno creato tre gruppi di topi: uno trattato con antibiotici (ABX), uno di controllo (antibiotici + 4,4′-DDE) e uno con antibiotici, trapianto di B. ovatus ed esposizione a 4,4′-DDE (BO).
Dopo l’esposizione al pesticida, sono stati osservati notevoli cambiamenti nella composizione microbica dei topi e livelli rilevabili di 4,4′-DDE nei loro organi. I metaboliti associati a B. ovatus, identificati nello studio in vitro, sono stati ritrovati anche nei tessuti dei topi, come la guanina nelle feci e la citidina-difosfato (CDP)-etanolammina nei polmoni. È emerso che l’aggiunta di B. ovatus ha influenzato i processi metabolici dell’ospite, con un impatto particolare sul metabolismo dei lipidi. Ad esempio, sono aumentati i livelli di 28 lipidi nel cervello, mentre si è osservata una significativa diminuzione di lipidi nel retto dei topi trattati con B. ovatus.

Inoltre, l’aggiunta di B. ovatus ha aumentato significativamente gli acidi grassi a catena corta (SCFA) e gli acidi biliari secondari nel fegato, cervello e intestino dei topi, suggerendo una modulazione del sistema immunitario dell’ospite attraverso l’asse intestino-fegato-cervello. Infatti, nel gruppo BO sono stati osservati livelli significativamente più bassi dei recettori Toll-like 4 (TLR4) e del fattore di differenziazione mieloide 88 (MyD88) nel cervello, indicando un’attenuazione dell’infiammazione attraverso la via infiammatoria TLR4/NF-κB.
Un atlante per il futuro: cosa ci portiamo a casa?
Questo studio è importantissimo perché ci fornisce una sorta di “atlante” completo delle interazioni tra pesticidi, microbiota intestinale e metaboliti. Ha identificato le specie batteriche più sensibili, le vie metaboliche più colpite e i metaboliti specifici associati a determinati batteri. Questi dati sono una risorsa preziosa per capire meglio i meccanismi attraverso cui i pesticidi influenzano la nostra salute.
Certo, la strada è ancora lunga. Questo studio si è concentrato su un sottogruppo di batteri e pesticidi, e ci sono ancora molte interazioni da esplorare. Le ricerche future dovranno integrare approcci multi-omici (genomica, trascrittomica, proteomica) per avere un quadro ancora più completo. Tuttavia, i risultati attuali, che includono profili metabolici specifici per batterio-pesticida, offrono una base solida per identificare biomarcatori e sviluppare strategie preventive.
Insomma, la prossima volta che pensiamo ai pesticidi, ricordiamoci che non si tratta solo di quello che mangiamo, ma di come queste sostanze dialogano, e a volte litigano, con il complesso e meraviglioso mondo che vive dentro di noi. Un equilibrio delicato che merita tutta la nostra attenzione!
Fonte: Springer Nature
